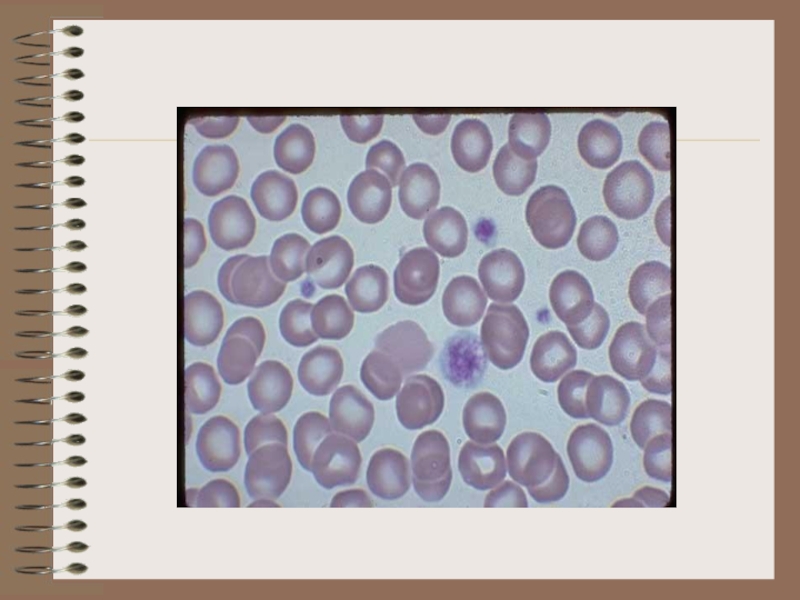
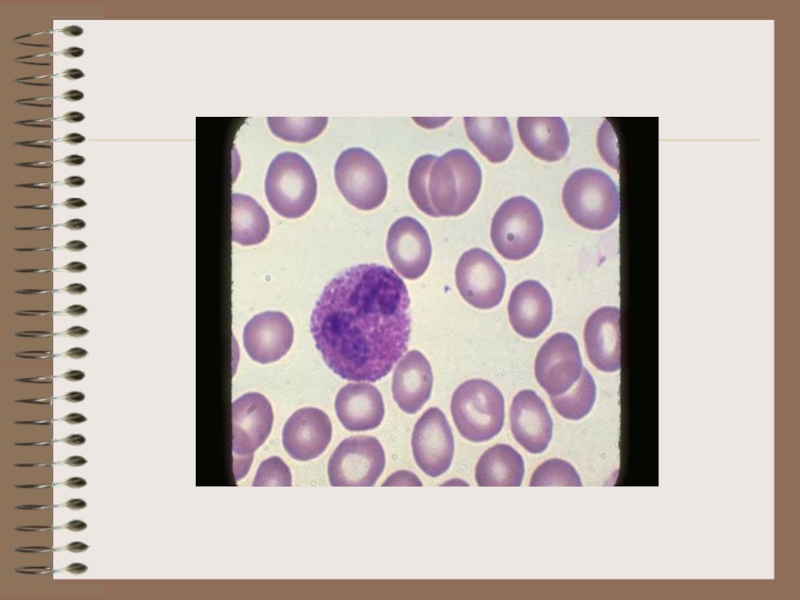

- Главная
- Разное
- Дизайн
- Бизнес и предпринимательство
- Аналитика
- Образование
- Развлечения
- Красота и здоровье
- Финансы
- Государство
- Путешествия
- Спорт
- Недвижимость
- Армия
- Графика
- Культурология
- Еда и кулинария
- Лингвистика
- Английский язык
- Астрономия
- Алгебра
- Биология
- География
- Детские презентации
- Информатика
- История
- Литература
- Маркетинг
- Математика
- Медицина
- Менеджмент
- Музыка
- МХК
- Немецкий язык
- ОБЖ
- Обществознание
- Окружающий мир
- Педагогика
- Русский язык
- Технология
- Физика
- Философия
- Химия
- Шаблоны, картинки для презентаций
- Экология
- Экономика
- Юриспруденция
Фізіологія системи крові. Еритрон. Групи крові презентация
Содержание
- 1. Фізіологія системи крові. Еритрон. Групи крові
- 2. Поняття про систему крові 1) кров,
- 4. Функції крові а) дихальна функція б)
- 7. Кількість (об'єм) крові, поняття про її депонування
- 9. Форменні елементи. У 1 літрі циркулюючої
- 10. Плазма. 90 % плазми крові складає вода,
- 12. БІЛКИ ПЛАЗМИ Білки плазми у дорослих у
- 13. Функціональне значення білків плазми Альбумін. Він
- 14. Буферні системи крові Підтримування постійної кислотно-лужної рівноваги
- 15. 2. Фосфатний буфер – це суміш однозаміщеного
- 16. 4. Гемоглобіновий буфер. По суті є два
- 17. Оцінка кислотно-лужного балансу здійснюється за такими показниками:
- 18. Функції еритроцитів 1. Транспортна. Еритроцити переносять:
- 20. Регуляція еритропоезу Регуляція еритропоезу здійснюється нервовими
- 22. Кровотворення підсилюється гормонами передньої частини гіпофіза, надниркових
- 23. Швидкість осідання еритроцитів (ШОЕ) Щільність або
- 26. Гемоглобін Основна фізіологічна функція – обмін О2
- 28. У скелетному та серцевому м'язах знаходиться м'язовий
- 29. СХЕМА КРОВОТВОРЕННЯ
- 31. Функції лейкоцитів. 1. Захисна: а) здатні до
- 33. Кількість лейкоцитів та їх зміни. У судинному
- 34. Причини фізіологічних лейкоцитозів а) харчовий –
- 35. Лейкоцитопоез. Лейкоцити поділяються на дві групи:
- 36. Лейкопоез
- 38. Гранулопоез. Схема гранулопоезу: І клас: стовбурова
- 39. Моноцитопоез. Моноцитопоез має однаковий початок з гранулопоезом.
- 41. Лімфоцитопоез. Лімфоцитопоез здійснюється за такою схемою:
- 42. Регуляція лейкопоезу. Мало досліджена роль нервової системи,
- 44. Функціональні особливості нейтрофільних гранулоцитів. Знаходяться в кровоносному
- 46. Функціональні особливості еозинофільних гранулоцитів. Період перебування
- 48. Функціональні особливості базофільних гранулоцитів. Час перебування цих
- 50. Функціональні особливості лімфоцитів Лімфоцити утворюються в
- 51. Частина лімфоїдних клітин не диференціюється в органах
- 52. Функції Т-лімфоцитів: 1. Імунологічна пам'ять. 2. Противірусний
- 54. Функціональні особливості моноцитів Утворюються в кістковому мозку.
- 55. Система мононуклеарних фагоцитів Сукупність тканинних макрофагів, об'єднаних
- 57. Лейкоцитарна формула. У клініці важливе значення
- 58. Лейкоцитарна формула Гранулоцити
- 59. Індекс ядерного зсуву нейтрофілів При дослідженні лейкоцитарної
- 60. Група крові – це сукупність
- 61. Історія відкриття груп крові У 1900
- 62. Еритроцитарні групи крові Аглютинація еритроцитів відбувається
- 63. До уваги! У крові кожної людини міститься
- 64. Система АВ0 За цією системою еритроцити людини
- 67. Антитіла системи СDE Природніх антитіл у
- 71. Лейкоцитарні групи крові Вперше відомості за
- 72. Загальні антигени лейкоцитів (система HLA – human
- 74. Антигени гранулоцитів Ця система антигенів характерна
- 75. Лімфоцитарні антигени Лімфоцитарні антигени, характерні тільки
- 76. Сироваткові групи крові Найбільше значення серед
- 77. Сироваткові групи Альфа-1-глобуліни. У ділянці альфа-1-глобулінів відмічається
- 78. Переливання крові Основне правило переливання: переливати тільки
- 79. Фізіологічні ефекти перелитої крові 1. Стимулюючий –
- 80. Групи кровозамінників 1. Гемодинамічні – для нормалізації
- 81. Загальна характеристика системи гемостазу Гемостаз
- 83. Особливо тісно пов’язані між собою перші два
- 84. ДЯКУЮ ЗА УВАГУ!
Слайд 2Поняття про систему крові
1) кров,
2) органи кровотворення,
3) органи кроворуйнування
4) регуляторний апарат об'єднано в одну систему крові.
Кров–це рідка тканина внутрішнього середовища організму, яка складається з плазми та клітин – червоних кров'яних тілець, червонокрівців або еритроцитів, білих кров'яних тілець, білокрівців або лейкоцитів і кров'яних пластинок або тромбоцитів.
Слайд 4Функції крові
а) дихальна функція
б) трофічна функція
в) екскреторна функція
г) гуморально-регуляторна
г) теплообмінна функція
д) захисна функція
Слайд 7Кількість (об'єм) крові, поняття про її депонування
В організмі дорослої людини в
Частина крові знаходиться в депо:
у печінці – до 20 %,
у шкіро-підшкірних судинних сплетіннях – до 10 %,
у селезінці – до 1,5-2 % кількості крові. Депонована кров порівняно із кров'ю в судинах циркулює в 10-20 разів повільніше, містить більше форменних елементів.
Слайд 9Форменні елементи.
У 1 літрі циркулюючої крові чоловіків знаходиться 4,0-5,1•1012/л або
Кількість лейкоцитів у дорослих 4-9•109/л або 4-9 Г/л, у новонароджених 16,7-30,0•109/л або 16,7-30,0 Г/л.
Кількість тромбоцитів у дорослих 180-320•109/л або 180-320 Г/л. У дітей кількість тромбоцитів на рівні дорослих.
Слайд 10Плазма.
90 % плазми крові складає вода, до 8 % – білка,
Було встановлено, що еритроцити не змінюються при додаванні їх до 0,9 % р-ну NaCl.
Слайд 12БІЛКИ ПЛАЗМИ
Білки плазми у дорослих у нормі складають 65-85 г/л. Серед
α1 глобулінів – 1-4 г/л
α2 глобулінів – 4-8 г/л
β глобулінів – 6-12 г/л
γ глобулінів – 8-16 г/л
Фібриноген у дітей та дорослих дорівнює 2-4 г/л. Плазма позбавлена цього білка називається сироваткою.
Слайд 13Функціональне значення білків плазми
Альбумін. Він на 80 % визначає онкотичний тиск.
Альбуміни утворюються в печінці. За добу синтезується 17 г альбумінів.
Глобуліни. У складі фракції α1-глобулінів знаходяться білки зв'язані з вуглеводами. До фракції α2-глобулінів відноситься білок церулоплазмін, тироксизв'язуючий білок, вітамін В12-зв'язуючий глобулін, ангіотензин. До β-глобулінів відносяться перенощики ліпідів, полісахаридів, заліза.
Антитіла є в основному γ-глобулінами. Глобуліни синтезуються в печінці, кістковому мозку, селезінці, лімфатичних вузлах. За добу синтезується 5 г глобуліну.
Фібриноген. (2-4 г/л). Цей білок приймає участь в утворенні згустку крові. Так як і альбумін фібриноген утворюється виключно в печінці.
Слайд 14Буферні системи крові
Підтримування постійної кислотно-лужної рівноваги крові забезпечується буферними системами:
1. Бікарбонатний
Н2СО3 + ОН– ⇄ НСО3– + Н2О,
а при нагромадженні іонів водню –
НСО3– + Н+ ⇄ Н2СО3
Слайд 152. Фосфатний буфер – це суміш однозаміщеного фосфату Н2РО4 (слабка кислота)
Н2РО4– + ОН– ⇄ НРО42– + Н2О,
а при нагромадженні іонів водню:
НРО42– + Н+ ⇄ Н2О4–
3. Білковий буфер. Він забезпечується білками плазми, особливо альбумінами. Їх амінокислоти мають здатність до іонізації, тобто володіють амфотерними властивостями. Білковий буфер можна позначити так: RСООН/RООС–. При надлишку лужних іонів підтримування кислотно-лужної рівноваги відбувається за реакцією:
RСООН + ОН– ⇄ RООС– + Н2О,
а при нагромадженні іонів водню:
RСОО– + Н+ ⇄ RООН
Слайд 164. Гемоглобіновий буфер. По суті є два гемоглобінових буфери – один
НHb + ОН– ⇄ Нb– + Н2О;
НHbО2 + ОН– ⇄ НbО2– + Н2О,
а при нагромадженні іонів водню:
Нb– + Н+ ⇄ ННb;
НbО2– + Н+ ⇄ ННbО2
Слайд 17Оцінка кислотно-лужного балансу здійснюється за такими показниками:
1. рН (від англ. power
2. Напруження СО2 – рСО2, яке в нормі дорівнює 5,3-6,1 кПа (40-46 мм рт.ст.).
3. Стандартний бікарбонат, міжнародне позначення SB (standart bikarbonate) – розрахунковий показник. За стандартних умов складає 20-27 ммоль/л.
4. Істинний, дійсний бікарбонат, міжнародне позначення АВ (actual bikarbonate), дорівнює 190-25 ммоль/л.
5. Надлишок (дефіцит) основ, міжнародне позначення ВЕ (D) (base ecxess (deficit) рівняється ±2,3 ммоль/л.
6. Сума основ всіх буферних систем крові, міжнародне позначення ВВ (batter bases) дорівнює 40-60 ммоль/л.
Слайд 18Функції еритроцитів
1. Транспортна. Еритроцити переносять: О2, СО2, NO, адсорбовані білки, медикаменти,
2. Забезпечення кислотно-лужної рівноваги.
3. Підтримання іонного складу плазми.
4. Гемостатична.
Слайд 20Регуляція еритропоезу
Регуляція еритропоезу здійснюється нервовими та гуморальними механізмами; симпатична інервація стимулює
Велике значення відіграє в регуляції еритропоезу еритропоетин. Кількість еритропоетину збільшується при зменшенні в організмі кисню. Еритропоетин впливає в першу чергу на еритропоетинчутливу клітину – посилює її проліферацію, прискорює синтез гемоглобіну в усіх клітинах. Гормон збільшує кровообіг навколо еритропоетичної тканини і тим самим збільшує вихід в кров ретикулоцитів. Еритропоетин вже використовують як медикаментозний препарат при лікуванні анемій.
Слайд 22Кровотворення підсилюється гормонами передньої частини гіпофіза, надниркових залоз, щитоподібної залози. Чоловічі
В організмі утворюються особливі речовини які гальмують еритропоез – інгібітори еритропоезу. Їх вміст зростає при збільшенні кількості еритроцитів, яка не відповідає потребам тканин у кисні. Інгібітори еритропоезу подовжують цикл поділу еритроїдних клітин, гальмують в них синтез гемоглобіну.
Слайд 23Швидкість осідання еритроцитів (ШОЕ)
Щільність або відносна густина еритроцитів (1,098) вища, ніж
Слайд 26Гемоглобін
Основна фізіологічна функція – обмін О2 і СО2, тобто дихальна. Виходячи
До дихальних пігментів відноситься гемоглобін та міоглобін.
Вміст гемоглобіну в крові чоловіків складає в середньому 130-160 г/л, а в жінок – 120-140 г/л. У крові новонародженого вміст гемоглобіну складає 192-232 г/л. Протягом першого року вміст гемоглобіну зменшується, а потім поступово зростає до рівня дорослих.
Гемоглобін складається з білка глобіну, який має 4 ланцюжки, і чотирьох молекул гема. 96 % від маси молекули гемоглобіну займає глобін, 4 % – гем. Гем є активною групою гемоглобіну. Основну роль у діяльності гемоглобіну відіграє залізо. У молекулі гемоглобіну знаходиться 4 атоми заліза
Слайд 28У скелетному та серцевому м'язах знаходиться м'язовий гемоглобін, що називається міоглобіном.
У серці знаходиться 1,5 % всього міоглобіну організму. Його вміст може збільшитися під впливом регулярних фізичних навантажень.
Міоглобін здатний зв'язати кисень до 14 % загальної кількості кисню в організмі. Ця властивість відіграє важливу роль у постачанні киснем м'язів у фазу скорочення. При цьому перетискаються судини і кровообіг у деяких їх ділянках припиняється. Але завдяки наявності кисню, зв'язаного з міоглобіном, протягом певного часу зберігається забезпечення м'язових волокон киснем.
У нормі в сироватці дорослих осіб є незначна кількість міоглобіну (у жінок – 20-50 мкг/л; у чоловіків – 30-70 мкг/л). Але поява міоглобіну в крові в значній кількості свідчить про порушення структури м'язових тканин – серця, скелетних м'язів.
Міоглобін.
Слайд 31Функції лейкоцитів.
1. Захисна:
а) здатні до амебоїдних рухів, можуть виходити через стінку
володіють позитивним хемотаксисом по відношенню до бактеріальних токсинів, продуктів розпаду бактерій, грибків, клітин організму і комплексів антиген-антитіло; здатні оточувати чужерідні тіла, захоплювати їх у цитоплазму і перетравлювати (фагоцитоз).
б) синтез антитіл, речовин ферментної природи.
2. Транспортна (транспортують ферменти: протеази, пептидази, фізіологічно-активні речовини: гістамін, гепарин, серотонін.
3. Метаболічна (синтезують білки, глікоген, фосфоліпіди).
4. Регенераторна (виділяють трофони, що приймають участь у регенераторних процесах).
Слайд 33Кількість лейкоцитів та їх зміни.
У судинному руслі циркулює біля 20 %
У крові здорової людини є 4•109/л-9•109/л лейкоцитів або 4 Г/л-9 Г/л.
Якщо кількість лейкоцитів менша 4 Г/л, то говорять про лейкопенію. Лейкопенія зустрічається тільки при патології.
Якщо кількість лейкоцитів перевищує 9 Г/л, то це лейкоцитоз. Розрізняють лейкоцитози: фізіологічні і патологічні.
Кількість лейкоцитів коливається протягом доби – максимум спостерігається у вечірній час.
Слайд 34
Причини фізіологічних лейкоцитозів
а) харчовий – після прийому їжі, особливо білкової;
б) міогенні
в) стресовий – після психоемоційного навантаження;
г) у вагітних;
д) овуляційний;
е) у новонароджених. Кількість лейкоцитів у них складає 16,7-30 Г/л. У кінці першого місяця життя кількість лейкоцитів зменшується і складає 12-15 Г/л. У кінці першого року життя – 7,0-12,5 Г/л. У віці 10-14 років кількість лейкоцитів майже досягає величин дорослих і складає 4,5-10 Г/л.
Причини патологічних лейкоцитозів
запалення, інфекційні процеси
Слайд 35Лейкоцитопоез.
Лейкоцити поділяються на дві групи:
гранулоцити (зернисті) і
агранулоцити (незернисті).
До
- нейтрофіли,
- еозинофіли,
- базофіли,
До агранулоцитів відносять
– лімфоцити
- моноцити.
Відповідно лейкоцитопоез (лейкопоез) включає гранулоцитопоез (гранулопоез)
лімфоцитопоез (лімфопоез)
моноцитопоез (монопоез).
Слайд 38Гранулопоез.
Схема гранулопоезу:
І клас: стовбурова клітина →
ІІ клас: попередниця мієлопоезу
ІІІ клас: колонієутворююча клітина →
ІV клас: мієлобласт – морфологічно розрізняється →
V клас: промієлоцит →
V клас: мієлоцит →
V клас: метамієлоцит →
VI клас: паличкоядерні клітини →
VI клас: сегментоядерні клітини.
Дозрівання гранулоцитів триває 8-10 діб, але вихід у кров відбувається тільки через 3-5 діб після дозрівання.
Слайд 39Моноцитопоез.
Моноцитопоез має однаковий початок з гранулопоезом. Дозрівання здійснюється у такій послідовності:
стовбурова клітина →
попередниця мієлопоезу →
колонієутворююча клітина →
монобласт →
промоноцит →
моноцит.
Слайд 41Лімфоцитопоез.
Лімфоцитопоез здійснюється за такою схемою:
стовбурова клітина →
клітина попередниця лімфоцитопоезу
лімфобласт →
пролімфоцит →
лімфоцит.
Слайд 42Регуляція лейкопоезу.
Мало досліджена роль нервової системи, хоча є значна іннервація кровотворних
Встановлено, що продукти розпаду тканин, лейкоцитів, мікробів і їх токсинів впливають на утворення лейкоцитів.
Всі впливи опосередковують свою дію на кістковий мозок через лейкопоетини, які утворюються в макрофагах кісткового мозку.
Слайд 44Функціональні особливості нейтрофільних гранулоцитів.
Знаходяться в кровоносному руслі максимум до 20 годин,
Нейтрофіли фагоцитують бактерії, грибки, продукти розпаду тканин і розщеплюють їх своїми ферментами перекисом водню.
Крім реакції на інфекцію, нейтрофіли також секретують транскобаламін.
За нейтрофілами можна визначити стать людини: при наявності жіночого генотипу нейтрофіли "барабанні палички".
Слайд 46Функціональні особливості еозинофільних гранулоцитів.
Період перебування еозинофілів в крові дуже короткий.
Функції: 1) антиалергічна; 2) фагоцитарна.
Еозинофіли містять гістаміназу, яка нейтралізує гістамін, що є у великій кількості при алергії.
Слайд 48Функціональні особливості базофільних гранулоцитів.
Час перебування цих клітин у кров'яному руслі близько
Слайд 50Функціональні особливості лімфоцитів
Лімфоцити утворюються в лімфатичних вузлах, селезінці, загрудинній залозі,
Вони відіграють основну роль у формуванні імунітету і здійснюють імунний нагляд.
Після кісткового мозку частина лімфоцитів проходить диференціацію у тимусі (загрудинній залозі) і перетворюються в Т-лімфоцити. Інші лімфоцити проходять диференціацію в лімфоїдній тканині мигдаликів, апендикса, пейєрових бляшках кишок - В-лімфоцити.
Слайд 51Частина лімфоїдних клітин не диференціюється в органах імунної системи. Ці клітини
Кількість Т-лімфоцитів складає 0,6-1,8 Г/л; В-лімфоцитів – 0,3-0,5 Г/л і нульові – 0,1-0,3 Г/л.
10-20 % лімфоцитів живуть від декількох годин до 7 днів, а до 80-90 % – до 100-200 днів.
До короткоживучих відносяться В-лімфоцити. До довгоживучих – Т-лімфоцити.
Слайд 52Функції Т-лімфоцитів:
1. Імунологічна пам'ять.
2. Противірусний імунітет, завдяки виробленню інтерферону.
3. Протитканинний імунітет,
4. Регулюють фагоцитарну активність зокрема нейтрофілів.
Функції В-лімфоцитів:
1. Імунологічна пам'ять.
2. Специфічний (гуморальний) імунітет. Ця функція можлива завдяки перетворенню В-лімфоцитів у плазмоцити.
Слайд 54Функціональні особливості моноцитів
Утворюються в кістковому мозку. У крові перебувають близько 72
Слайд 55Система мононуклеарних фагоцитів
Сукупність тканинних макрофагів, об'єднаних спільним походженням, будовою і функцією
Специфічними функціональними особливостями макрофагів є фагоцитоз мікроорганізмів, пухлинних клітин, збір і спрямування антигенного матеріалу до лімфоцитів, утворення фактору росту тканин, піноцитоз.
Слайд 57Лейкоцитарна формула.
У клініці важливе значення надається кількісному співвідношенню окремих форм лейкоцитів,
Слайд 58Лейкоцитарна формула
Гранулоцити
Базофіли лімфоцити
0-0,01 0,18-0,37
Еозинофіли моноцити
0,005-0,05 0,03-0,11
Нейтрофіли
Метамієлоцити
0-0,01
Паличкоядерні
0,01-0,06
Сегментоядерні
0,47-0,72
Слайд 59Індекс ядерного зсуву нейтрофілів
При дослідженні лейкоцитарної формули враховують індекс ядерного зсуву
ІЯЗ = (мієлоцити + юні + паличкоядерні) : сегментоядерні
У нормі ІЯЗ дорівнює 0,06-0,09.
Зсув вліво свідчить про подразнення кісткового мозку, коли ІЯЗ > 0,09.
Зсув вправо свідчить про пригнічення кровотворення, якщо ІЯЗ < 0,06.
Слайд 60 Група крові – це сукупність нормальних антигенів у певних компонентах крові,
Належність людини до тої чи іншої групи крові є її індивідуальною біологічною особливістю з раннього ембріонального періоду. Вона не змінюється протягом життя.
Групові антигени знаходяться в формених елементах, плазмі крові, клітинах і тканинах, секретах (слині, амніотичній рідині, шлунково-кишковому соку).
Розрізняють групи крові: еритроцитарні,
лейкоцитарні,
сироваткові.
Слайд 61Історія відкриття груп крові
У 1900 році австрійський лікар Карл Ландштейнер опублікував
Якщо змішати на претметному склі кров, взяту від різних осіб, що робили Ландштейнер і Янський, то в більшості випадків відбудеться склеювання або аглютинація еритроцитів.
Аглютинація (лат agglutinatio – склеювання) – це процес незворотнього склеювання еритроцитів під впливом антитіл. Він, як правило, супроводжується, гемолізом. Те ж відбувається і в судинному руслі при переливанні несумісної крові.
Слайд 62Еритроцитарні групи крові
Аглютинація еритроцитів відбувається в результаті реакції антиген-антитіло. У мембрані
Слайд 63До уваги!
У крові кожної людини міститься індивідуальний набір специфічних еритроцитарних аглютиногенів.
На практиці в даний час у нас враховуються в основному дві антигенні системи – це АВ0 і СDЕ.
Слайд 64Система АВ0
За цією системою еритроцити людини поділені в залежності від антигенного
без антигенів (зараз відомо, що це антиген Н),
з антигенами А, В, АВ.
У плазмі відповідно знаходяться природні антитіла, що умовно позначаються: αβ; β; α і відсутні.
Таким чином у людей розрізняють такі комбінації антигенів і антитіл в системі АВ0:
0(І)αβ ;
А(ІІ)β ;
В(ІІІ)α;
АВ(ІV).
Слайд 67Антитіла системи СDE
Природніх антитіл у групах крові системи резус немає.
Механізм розвитку резус конфлікту при вагітності: імунні антитіла, що утворилися в організмі резус-негативної жінки, вагітної резус-позитивним плодом, мають здатність проникати через плаценту в організм плода, викликати гемоліз його еритроцитів. Під час пологів у кров новонародженої дитини поступає багато антитіл і розвивається гемолітична хвороба.
Антитіла новонароджений може отримати і з молоком матері.
Слайд 71Лейкоцитарні групи крові
Вперше відомості за лейкоцитарні групи одержав французький дослідник Дассет
Зараз налічується більше 40 антигенів лейкоцитів, які умовно поділяються на три антигенні системи:
1. Загальні антигени лейкоцитів.
2. Антигени гранулоцитів.
3. Антигени лімфоцитів.
Слайд 72Загальні антигени лейкоцитів (система HLA – human leucocyte antigene)
Згідно рекомендацій ВООЗ
Генетично HLA-антигени належать до 4 підлокусів (А,В,С,D), кожний з яких об'єднує алельні антигени. Найбільш вивченим є сублокуси А і В. Наприклад, HLA-А1, HLA-А2, HLA-А3, HLA-А5, HLA-А7, HLA-А8.
Для першого підлокуса кількість антигенів становить 19, для другого – 20.
Антигени HLA знайдено й у клітинах різних органів і тканин (шкірі, печінці, нирках, селезінці та інших). Невідповідність донора і реціпієнта за ними супроводжується розвитком реакції тканинної несумісності. Тому встановлення цих антигенів використовують для тканинного типування при підборці для трансплантації донорів з подібним HLA-фенотипом.
Слайд 74Антигени гранулоцитів
Ця система антигенів характерна тільки для клітин мієлоїдного ряду,
Відомо три гранулоцитарних антигени: NA-1; NA-2; NВ-1.
Встановлено, що антитіла проти антигенів гранулоцитів викликають короткочасне зниження кількості нейтрофілів у новонароджених.
Після гемотрансфузій можуть бути фібрильні реакції обумовлені тим, що в плазмі реципієнта будуть антитіла проти антигенів, внаслідок чого виділятимуться пірогенні речовини.
Слайд 75Лімфоцитарні антигени
Лімфоцитарні антигени, характерні тільки для клітин лімфоїдної тканини.
Відомий поки
Слайд 76Сироваткові групи крові
Найбільше значення серед груп сироваткових білків має генетична неоднорідність
Відомі дві системи імуноглобулінів Gm і Inv.
Система Gm нараховує більше 20 антигенів крові, тобто 20 груп крові Gm (1) і Gm (2) і т.д., а
система Inv має три антигени, тобто 3 групи крові: Inv (1), Inv (2), Inv (3).
Слайд 77Сироваткові групи
Альфа-1-глобуліни. У ділянці альфа-1-глобулінів відмічається великий поліморфізм. Серед них виявлено
Альфа-2-глобуліни. У цій ділянці альфа-2-глобулінів розрізняють поліморфізм, зокрема, церулоплазміну.
Розрізняють 4 різновиди церулоплазміну (Ср): Ср А; Ср АВ; Ср В і Ср ВС. Найчастіше зустрічається група Ср В.
Бета-глобуліни. До них відноситься трансферин (Тf).
Розрізняють такі групи: ТfС, ТfD та інші.
Слайд 78Переливання крові
Основне правило переливання: переливати тільки одногрупну кров. Перед переливанням крові
Проба на сумісність у системі АВ0 направлена на виявлення антитіл в крові реципієнта до еритроцитів донора.
Проба на резус-сумісність направлена на виявлення антиеритроцитарних резус-антитіл.
Біологічна проба (трьохразова проба).
Слайд 79Фізіологічні ефекти перелитої крові
1. Стимулюючий – стимулює функції різних систем організму
2. Гемопоетичний – підсилює кровотворення.
3. Імунологічний – підсилює захисні сили організму за рахунок введення антитіл, оксонінів.
4. Живильна – з кров'ю вводяться поживні речовини.
Слайд 80Групи кровозамінників
1. Гемодинамічні – для нормалізації порушень гемодинаміки.
2. Дезинтоксикаційні – для
3. Препарати для парентерального живлення:
а) білкові гідролізати;
б) розчини амінокислот;
в) препарати жирової емульсії.
4. Регулятори водно-сольового і кислотно-лужної рівноваги:
а) сольові розчини;
б) осмодіуретики.
5. Кровозамінники з функцією перенесення кисню.
6. Кровозамінники комплексної дії.
Слайд 81
Загальна характеристика системи гемостазу
Гемостаз – фізіологічна система, яка попереджує крововтрату та
Функціонально-структурними компонентами системи гемостазу є:
1. стінка кровоносних судин;
2. клітини крові (в основному – тромбоцити);
3. ферментні і неферментні системи плазми.
Слайд 83Особливо тісно пов’язані між собою перші два компоненти, внаслідок чого їх
Другий механізм гемостазу – вторинний, коагуляційний гемостаз або зсідання крові.